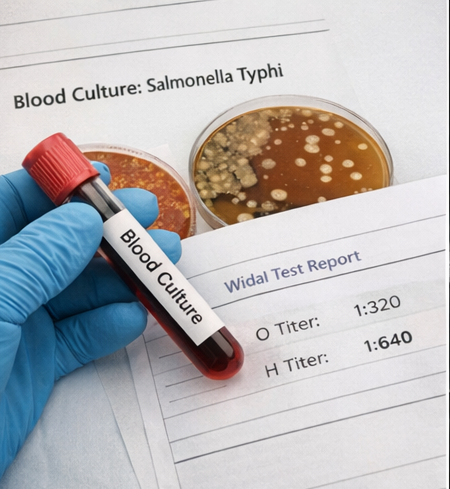

Enteric fever is a systemic infectious disease caused by Salmonella enterica serovar Typhi or Paratyphi, characterized by prolonged fever and multisystem involvement. Although most cases respond to timely antimicrobial therapy, severe complications may occur in untreated or partially treated disease. Intestinal hemorrhage is a recognized and potentially life-threatening complication resulting from necrosis and ulceration of Peyer’s patches in the terminal ileum. It typically presents during the second or third week of illness and may manifest as melena, hematochezia, anemia, or hemodynamic instability. Diagnosis relies on clinical suspicion supported by laboratory investigations, blood cultures, imaging, and endoscopic evaluation in selected cases. Management involves prompt resuscitation, appropriate antibiotics, blood transfusion when indicated, and close monitoring, with surgical intervention reserved for refractory bleeding or perforation. This case report describes a young adult male who developed acute lower gastrointestinal bleeding during enteric fever, highlighting clinical features, diagnostic workup, therapeutic approach, and outcome.
Enteric fever remains a significant public health concern in many low- and middle-income countries, particularly in regions with inadequate sanitation and limited access to clean water. The disease is caused primarily by Salmonella Typhi and less commonly by Salmonella Paratyphi. Transmission occurs through ingestion of contaminated food or water.
The pathogenesis involves invasion of intestinal lymphoid tissue, bacteremia, and systemic dissemination. The organism localizes in Peyer’s patches of the terminal ileum, leading to hyperplasia, necrosis, and ulcer formation. These intestinal ulcers may erode into submucosal vessels, resulting in hemorrhage, or may progress to perforation.
Intestinal hemorrhage, though less common in the antibiotic era, remains a serious complication. It may range from occult bleeding to massive gastrointestinal hemorrhage causing hypovolemic shock. Early recognition and prompt management are essential to reduce morbidity and mortality. This report presents a case of enteric fever complicated by intestinal hemorrhage and discusses clinical evaluation and therapeutic considerations.
A 22-year-old male presented to the emergency department with complaints of high-grade fever for 12 days, associated with generalized weakness, abdominal discomfort, and reduced appetite. The fever was insidious in onset, persistent, and associated with headache and malaise.

Three days prior to admission, he developed loose stools mixed with dark blood, followed by passage of black tarry stools. On the day of presentation, he experienced dizziness and near-syncope. There was no history of nonsteroidal anti-inflammatory drug use, alcohol intake, or prior gastrointestinal disease.
The patient reported recent travel to a rural area with questionable water hygiene. No significant past medical or surgical history was noted.
On examination, the patient appeared pale and lethargic.
Abdominal examination revealed mild distension and tenderness in the right lower quadrant without guarding or rigidity. No hepatosplenomegaly was detected. Bowel sounds were present.
Digital rectal examination confirmed melena. No signs of peritonitis were evident.
Based on history and presentation, the following differentials were considered:
The history of prolonged fever, epidemiological exposure, and systemic features suggested enteric fever.
Laboratory Findings
Blood cultures grew Salmonella Typhi, confirming the diagnosis of enteric fever.
Widal test showed significant titers for O and H antigens.
Stool examination confirmed presence of occult blood.
Imaging
Ultrasound abdomen showed mild ileal wall thickening without free fluid.
Contrast-enhanced computed tomography (CT) abdomen revealed segmental thickening of the terminal ileum with mucosal enhancement but no perforation.

Endoscopic Evaluation
After hemodynamic stabilization, colonoscopy was performed. Multiple oval-shaped ulcers were observed in the terminal ileum, with one actively oozing lesion consistent with typhoid ulceration. No other source of bleeding was identified.

A diagnosis of enteric fever complicated by intestinal hemorrhage secondary to ileal ulceration was established based on clinical presentation, positive blood culture, imaging, and endoscopic findings.
The patient was immediately managed with:

Broad-spectrum intravenous antibiotics were initiated and later tailored to intravenous ceftriaxone based on culture sensitivity results.
Medical Management
Bleeding decreased within 48 hours of initiating therapy. No further episodes of hematochezia were observed.
Hemoglobin stabilized at 10.2 g/dL after transfusion and treatment. Fever subsided by day 5 of antibiotic therapy.
The patient was discharged after 10 days with oral antibiotics to complete a 14-day course.
At 4-week follow-up, he remained asymptomatic with no recurrence of bleeding. Hemoglobin was 12.1 g/dL, and inflammatory markers had normalized.

Enteric fever is characterized by bacteremia and systemic involvement, with intestinal pathology being central to its complications. The terminal ileum is most commonly affected due to abundance of Peyer’s patches. Ulceration in this region predisposes to hemorrhage and perforation.
Intestinal hemorrhage typically occurs in the second or third week of illness and may present as melena or hematochezia. The degree of bleeding varies widely. Massive bleeding, although uncommon, can result in hemodynamic instability.
Leukopenia and anemia are common laboratory findings in complicated enteric fever. Blood culture remains the gold standard for diagnosis, particularly in early disease. Imaging helps exclude perforation, while endoscopy may identify the bleeding source in stable patients.
Management primarily involves supportive care and appropriate antibiotics. Ceftriaxone and azithromycin are commonly used in regions with multidrug resistance. Blood transfusion is indicated in significant anemia or ongoing bleeding.
Surgical intervention is reserved for persistent hemorrhage not responsive to conservative management or in cases complicated by perforation. Fortunately, most cases respond to medical therapy if identified early.
Early diagnosis and timely antimicrobial therapy have significantly reduced the incidence of severe complications. However, delayed presentation, antimicrobial resistance, and inadequate treatment remain risk factors for hemorrhagic complications.
Intestinal hemorrhage is a serious but manageable complication of enteric fever. High clinical suspicion is essential in patients presenting with prolonged fever and gastrointestinal bleeding, particularly in endemic regions. Blood culture confirmation, imaging, and endoscopic evaluation aid in diagnosis. Prompt resuscitation and appropriate antibiotic therapy are the cornerstones of management. Early intervention can prevent progression to life-threatening outcomes and ensure favorable recovery. Long-term follow-up is recommended to monitor recurrence or late complications.
Read more such content on @ Hidoc Dr | Medical Learning App for Doctors
1.
Babies Are Bleeding to Death as Parents Reject a Vitamin Shot Given at Birth
2.
Detecting pancreatic cancer through changes in body composition and metabolism
3.
In heavily pretreated DLBCL, Triplet Scores a Survival Victory.
4.
The pandemic had little impact on mental health symptoms.
5.
Men over 75 years old may be significantly more likely to commit suicide if they have cancer.
1.
From Muscle Soreness to Improved Endurance: The Benefits of Monitoring Lactic Acid Levels
2.
Unlocking the Mystery of Basilar Artery Stroke: A New Approach to Treatment
3.
Intrapancreatic Fat, Pancreatitis, and Cancer: Role of Cancer-Associated Fibroblasts
4.
Understanding Acute Intermittent Porphyria: Symptoms, Diagnosis and Treatment
5.
Exploring the Unknown: Unveiling the Mysteries of GIST Tumors
1.
International Lung Cancer Congress®
2.
Genito-Urinary Oncology Summit 2026
3.
Future NRG Oncology Meeting
4.
ISMB 2026 (Intelligent Systems for Molecular Biology)
5.
Annual International Congress on the Future of Breast Cancer East
1.
Treatment Sequencing Strategies in ALK + NSCLC Patients with CNS Diseases - Part II
2.
Managing ALK Rearranged Non-Small Cell Lung Cancer with Lorlatinib - Part II
3.
Virtual Case Study on Deep Vein Thrombosis (DVT) - An Initiative by Hidoc Dr.
4.
From Relapse to Remission : Chasing the Invisible and Redefining Long-Term Survival in Adult R/R B-Cell ALL
5.
Pazopanib: A Game-Changer in Managing Advanced Renal Cell Carcinoma - Part IV
© Copyright 2026 Hidoc Dr. Inc.
Terms & Conditions - LLP | Inc. | Privacy Policy - LLP | Inc. | Account Deactivation